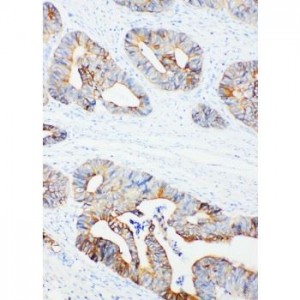
ROR1 Antibody

Immunohistochemistry (IHC)
Showing 217–228 of 1068 resultsSorted by latest
-

SCYL1BP1 Antibody
$330.00 Add to cart -

SCF Antibody
$330.00 Add to cart -

SAP97 Antibody
$365.00 Add to cart -

S100A9 Antibody
$365.00 Add to cart -

S100A9 Antibody
$365.00 Add to cart -

S100 alpha 6 Antibody
$365.00 Add to cart -

RUNX3 Antibody
$365.00 Add to cart -

RUNX1/AML1 Antibody
$365.00 Add to cart -

RTN3 Antibody
$330.00 Add to cart -
ROR1 Antibody
$330.00 Add to cart -

ROCK2 Antibody
$330.00 Add to cart -

ROCK2 Antibody
$365.00 Add to cart